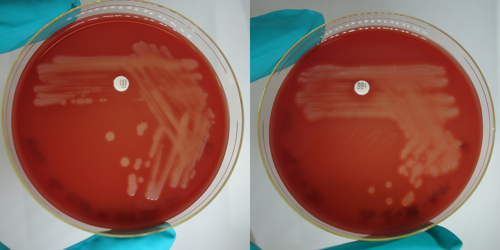

Diagnostikktrender 2023 gir et bilde av trender vi ser fra PCR, histopatologi og mikrobiologiprøver analysert hos PHARMAQ Analytiq i fjor, og omfatter prøver tatt ut fra laks i både sjø- og settefisklokaliteter i Norge. Vi har også bidratt med tall og materiale til Veterinærinstituttet sin Fiskehelserapport som ble lansert 12. mars.
Bilde: Forekomst av de hyppigste histopatologiske diagnosene på lokalitetsnivå i 2022 og 2023 (laks i sjø).
Gjellepatologi, spesielt karskader, har vært overrepresentert i vårt diagnostiske materiale dette året. Videre var andre ikke-spesifikke gjellelesjoner, som betennelse og hyperplasi, utbredt. Amøbegjellesykdom (AGD) og epiteliocyster var de smittsomme tilstandene som hyppigst ble påvist ved histopatologisk undersøkelse av gjellene. Bakterielle sår utgjorde også ett av de viktigste problemområdene i 2023. Moritella viscosa og i mindre grad Tenacibaculum finnmarkense ble hyppig isolert ved bakteriologisk undersøkelse i disse tilfellene.
Hjerte- og karproblemer var også utbredt i 2023. Kardiomyopatisyndrom (CMS) og hjerte- og skjelettmuskelbetennelse (HSMB) hadde et tilsvarende antall påvisninger som i 2022, men uspesifikk betennelse i hjertet (myokarditt), og myokarddegenerasjon ble også ofte registrert. Det ble også påvist en del tilfeller av hjertepigg og arteriosklerose.
Av øvrige systemiske sykdommer, har bildet i vårt diagnostiske materiale vært dominert av bakteriesykdommene pasteurellose, mykobakteriose og yersiniose, parasittsykdommene parvicapsulose og spironukleose og virussykdommen infeksiøs pankreasnekrose (IPN).
Utfelling av kalsium i nyrene (nefrokalsinose) og pseudobrankie ble ofte diagnostisert både i settefisk og hos laks i sjø, mens HSS (hemoragisk smoltsyndrom) hovedsakelig ble diagnostisert i ferskvannsfasen. Perlesnormaneten har påført store skader og høy dødelighet i de fleste regioner i 2023 og vi har også påvist gjelleskader og sår på en rekke saker der eksponering til perlesnormanet er oppgitt i anamnesen.

Bilde: Forekomst av de hyppigste gjellediagnosene på lokalitetsnivå i 2023 (laks i sjø).
Lamellære karskader (blødninger og tromber) er blant de vanligste histopatologiske funnene i gjeller. Disse skadene er uspesifikke og kan skyldes ulike faktorer, inkludert eksterne traumer fra håndteringsoperasjoner og avlivning, eksponering for skadelige stoffer i vannet (for eksempel maneter, inkludert perlesnormanet, alger og gjelleagens), samt systemiske bakterieinfeksjoner.
Subepitelial gjellebetennelse er en uspesifikk betennelse i gjellelamellene, og flere tilfeller antas å være knyttet til infeksjon eller sykdom forårsaket av parasitten Desmozoon lepeophtherii (Paranucleospora theridion).
Epiteliocyster er forårsaket av intracellulære bakterier (hovedsakelig Ca. Branchiomonas cysticola) ansamlet som cystestrukturer inne i epitelceller. Det er begrenset korrelasjon mellom positiv PCR og funn av epiteliocyster ved histopatologi. Likevel kan epiteliocyster spille en mulig rolle i uspesifikk gjellebetennelse og i tilfeller av kompleks gjellepatologi.
Gjellebetennelse i filament kan være forårsaket av skade fra vannbårent materiale eller som en del av systemiske bakterieinfeksjoner som pasteurellose, furunkulose, mykobakteriose og pseudomonas-infeksjon.
Hyperplastisk gjellebetennelse er kjennetegnet ved epitelhyperplasi og sammenvoksing av lameller. Disse endringene er typiske ved AGD, selv om det ikke alltid er mulig å påvise amøber i snittet ved histologisk undersøkelse. Denne typen gjellebetennelse er også beskrevet i forbindelse med andre agens (Desmozoon lepeophtherii (Paranucleospora theridion) og Ca. Branchiomonas cysticola)), og kan i tillegg skyldes skade etter eksponering for skadelig vannbårent materiale.
I tillegg til de nevnte diagnosene har vi observert flere tilfeller fra spesifikke områder/lokaliteter med kompleks gjellepatologi, som kan ha ulike infeksiøse og ikke-infeksiøse årsaker. Patologien kan inkludere en kombinasjon av AGD, karskader, subepitelial betennelse, betennelse i filament, epiteliocyster, apoptose av epitelceller med mer.

Bilde: Forekomst av amøber (Paramoeba perurans) påvist på lokalitetsnivå ved PCR i 2022 og 2023 (laks i sjø).
Bilde: Forekomst av gjelleagens (Branchiomonas cysticola, Paramoeba perurans, Desmozoon lepeophterii (Paranucleospora theridion) og salmon gill poxvirus)) på lokalitetsnivå påvist ved PCR i 2022 og 2023 (laks i sjø).
Våre tall viser en økning i påvisning av gjelleagens om høsten, spesielt for amøber (se figurer for forekomst av AGD og gjelleagens)), noe som samsvarer godt med tidligere kunnskap om sesongvariasjonen for amøbegjellesykdom (AGD).
De agensene som det oftest analyseres for på gjellene ved hjelp av RT-PCR inkluderer Paramoeba perurans, Ca. Branchiomonas cysticola, Desmozoon lepeophterii (Paranucleospora theridion) og salmon gill poxvirus (SGPV). De første påvisningene av AGD forekommer vanligvis i mai/juni, og antallet tilfeller øker gjennom sommeren, med en topp som inntreffer ca i september/oktober. Desmozoon lepeophterii (Paranucleospora theridion), Ca. B. cysticola og poxvirus kan påvises både hos frisk og syk fisk. Det er observert betydelige forskjeller i gjellepatologi og dødelighet blant fiskegrupper med tilsvarende ct-verdier for disse agensene, noe som betyr at det ikke alltid er en direkte sammenheng mellom PCR-resultater og omfanget av gjellesykdom.

Bilde: Forekomst av lamellære karskader på lokalitetsnivå etter måned i 2022 og 2023 (laks i sjø).
Det ble registrert lamellære karskader i histologiprøver sendt inn til oss fra alle regioner året rundt, med en liten økning i høstmånedene. Årsakene til denne økningen kan inkludere den økte aktiviteten knyttet til gjellesesongen, hyppigere håndteringsoperasjoner som lusebehandling og AGD-behandling, samt oppblomstring av alger, maneter, zooplankton og økt begroing av nøter.
Antall diagnoser av bakterielle sår var lik i både 2023 og 2022, med hovedsakelig forekomst om vinteren, som forventet.
Moritella viscosa og Tenacibaculum spp (hovedsakelig Tenacibaculum finnmarkense) ble hovedsakelig isolert om vinteren, i tråd med forventningene.
I 2023 var det en overvekt av Moritella viscosa varianter og den klassiske, ikke-viskøse typen, med få isolerte tilfeller av den klassiske typen Moritella viscosa, noe som samsvarer med trendene fra 2022.

Bilde: Forekomst av sår blant histopatologiske diagnoser på lokalitetsnivå etter måned i 2022 og 2023 (laks i sjø).

Bilde: Forekomst av sårbakterier (Moritella viscosa og Tenacibaculum spp) påvist ved mikrobiologi på lokalitetsnivå etter måned i 2022 og 2023 (laks i sjø).

Bilde: Forekomst av forskjellige varianter Moritella viscosa påvist ved mikrobiologi på lokalitetsnivå etter måned i 2022 og 2023 (laks i sjø).

Bilde: Bildet viser sår assosiert med Moritella viscosa i hud fra laks i sjø.
Bilde: Agarskåler med klassisk Moritella viscosa til venstre og variant til høyre. Bakteriene dyrkes på blodagar med salt. De to typene er svært like av farge og viser begge hemolyse (oppklaring av agarmediet rundt bakteriekoloniene). Klassisk M. viscosa beskrives ofte som ikke-viskøs, dvs. at bakteriekoloniene Ikke er trådtrekkende, mens variant M. viscosa har trådtrekkende (seige) kolonier.

Bilde: Forekomst av de hyppigst forekommende hjertediagnosene på lokalitetsnivå i 2023 (laks i sjø).
Kardiomyopatisyndrom (CMS) var omtrent på samme nivå i 2023 som forrige år med tanke på antall påvisninger. Sykdommen er utbredt i alle produksjonsområder, og affiserer oftest stor laks sent i produksjonssyklus, men kan også ramme yngre fisk tidlig etter sjøsetting og stamfisk. Sykdommen gir betydelige fiskevelferdsmessige utfordringer, i tillegg til store økonomiske tap da den rammer stor fisk som nærmer seg slakting.
Hjerte- og skjelettmuskelbetennelse (HSMB) hadde en svak nedgang i forekomst i 2023 sammenlignet med fjoråret. Sykdommen påvises hyppigst hos laks i sjø, men sees også hos settefisk.
Myokarddegenerasjon (Link: Artikkel i National Library of Medicine) observeres med økende forekomst hos laks og regnbueørret i sjø. Forandringen sees i den kompakte hjertemuskulaturen som lysere områder med degenerert/skadet hjertemuskulatur i områdene rundt forgreninger av koronarkarene. Typisk sykehistorie i slike tilfeller er at fisken har vært utsatt for stress, eksempelvis ikke-medikamentell lusebehandling, transport eller brå temperaturforandringer. Vi ser også denne type forandringer hos fisk med systemiske bakterieinfeksjoner. Det har vært en tilsynelatende stor økning fra 2022 til 2023, men noe av forklaringen ligger i at registrering for tilstanden ble innført midtveis i 2022. En interessant observasjon er at registreringene viser at tilstanden er mer prevalent enn både CMS og HSMB.

Bilde: Bildet viser vevssnitt fra hjerte fra laks. Det sees lysere områder med myokarddegenerasjon rundt forgreninger av koronararterier. E = epikard, K = kompakt hjertemuskulatur, S = spongiøs hjertemuskulatur, kk = forgreninger av koronararterier.
"Hjertepigg" (Link: Artikkel i National Library of Medicine) er et anatomisk fenomen som stadig ofteres påvises ved histopatologisk undersøkelse av yngel fra oppdrettlaks. Denne piggformede bruskstrukturen, som ligger ventralt for perikardialhulen, antas å kunne ha betydelige konsekvenser for hjertefunksjonen.
Hjertepiggen kan presse på hjertet og føre til innbuktninger i hjerteveggen. Bruskstrukturen varierer i størrelse og grad av innvirkning på hjertets morfologi. Noen ganger fører det til mildere innbuktning i ventrikkelveggen, mens andre ganger kan man se en kløft på ventrikkelens ventralside.
Hos større laks ser man ofte en fortykkelse av den kompakte hjertemuskulaturen ventralt i hjertet, og av og til betennelse i hjertets ytre hinne i det samme området. Disse forandringene kan være et resultat av den mekaniske irritasjonen forårsaket av bruskstrukturen. Årsaksforholdene rundt hjertepiggen er ikke fullt ut forstått, men en teori er at det kan skyldes ubalanse i veksten mellom hjertevevet og gjelleskjelettet.

Bilde: Mikroskopibilde av hjerte som viser en dyp innbuktning (piler) på ventralsiden av ventrikkelen. A= atrium, V= ventrikkel.
Arteriosklerose omfatter en gruppe tilstander med fortykket og forstivet arterievegg. Forandringene består av proliferasjon av glatt muskulatur og sees som «putedannelser» på innsiden av karveggen. Tilstanden forekommer hos både villaks og oppdrettslaks, men utbredelsen er ikke kjent. Pharmaq Analytiq startet med systematisk registrering av arteriosklerose midtveis i 2023, og vi er også involvert i forskningsprosjekter som skal undersøke forekomst, årsaksforhold og eventuelle sammenhenger med annen hjertepatologi. Arteriosklerose kan føre til nedsatt oksygentilførsel til den kompakte hjertemuskulaturen, og dermed disponere for stressrelatert dødelighet.

Bilde: Vevssnitt fra koronarkar fra laks i sjø. Bildet viser arteriosklerotiske forandringer i karveggen (piler).
Pasteurellose hos laks forårsakes av en bakterie som har fått det foreløpige navnet Pasteurella “atlantica genomovar salmonicida”. Antall påvisninger har ikke endret seg vesentlig fra 2022 til 2023. Sykdomsutbrudd sees ofte etter håndtering, behandling og andre typer stress. Syk fisk kan ha betennelse og blødninger i ulike organer, inkludert øye og hjerte. Det er ofte store mengde bakterier tilstede i de ulike vevene.
Rødmunnsjuke eller yersiniose hos laks forårsakes av bakterien Yersinia ruckeri. Denne sykdommen forekom tidligere mest hos yngel og settefisk. Nå ser man imidlertid yersiniose hos matfisk i sjø, og sykdomsutbrudd er ofte forbundet med håndtering, behandling og andre typer stress. I kroniske tilfeller finner man hvite knuter (granulomer) i bl.a. nyre og milt. Antall påvisninger har ikke endret seg vesentlig fra 2022 til 2023, hvor vi begge år har påvist Y. ruckeri i PCR-prøver fra 23 ulike lokaliteter. Vi har ikke mottatt utfyllende informasjon om vaksinestatus fra påvisningene, men stikkvaksinasjon mot sykdommen er utbredt.
Mykobakteriose (Link: Artikkel i Journal of Fish Diseases) ble påvist i 24 bekreftede tilfeller (immunhistokjemi, bakteriologisk undersøkelse eller PCR-undersøkelse) i tillegg til to saker med typiske histopatologiske forandringer og påvisning av syrefaste staver i 2023. Tilfellene var alle fra laks og kom fra to settefisklokaliteter og 18 matfisklokaliteter. Mycobacterium salmoniphilum ble påvist i alle tilfeller hvor bakteriene ble identifisert på artsnivå (sekvensering). I 11 tilfeller ble bakteriene kun identifisert som Mycobacterium sp.
Parvicapsulose og spironukleose (Link: Artikkel i Norsk Veterinær Tidsskrift) var omtrent like vanlige i 2023 som i 2022. For parvicapsulose ble de fleste tilfellene påvist om våren. I flertallet av de undersøkte tilfellene i 2023 (13 av 18 tilfeller) observerte vi moderat til rikelig forekomst av Parvicapsula pseudobranchiola knyttet til forandringer i pseudobrankien. På én lokalitet ble det registrert systemisk parvicapsulose, med påvisning av parasitten i blodkar i flere vev, inkludert øyne og gjeller. Spironukleose var også på omtrent samme nivå i 2023 som forrige år. Det var også vanlig at de fleste tilfellene av spironukleose og parvicapsulose hadde andre diagnoser, som for eksempel bakterielle sår, HSMB, forkalkning i pseudobankier og nefrokalsinose. Når det gjelder geografisk distribusjon, var de kliniske tilfellene lokalisert nord i landet.
Nefrokalsinose er hyppigst i settefiskfasen og forekommer gjennom hele året. Det observeres en del tilfeller av nefrokalsinose også i sjøen, med en liten økning i forekomsten fra april til juni. Antallet påviste tilfeller holder seg relativt stabilt, men det er en tendens til færre påvisninger i andre halvdel av 2023. Omfanget av utfellinger i nyrene varierer fra svært sparsomme eller tilfeldige funn til svært uttalt forekomst.
Hemoragisk smoltsyndrom (HSS) forekommer regelmessig i settefiskfasen og har ikke endret seg vesentlig i forekomst fra 2022-2023. Diagnosen stilles ved en kombinasjon av klinikk/anamnese og histopatologiske funn. Det finnes per i dag ingen annen metode for å diagnostisere tilstanden på.

Bilde: Forekomst av nefrokalsinose og hemoragisk smoltsyndrom (HSS) i 2023. Histopatologiske diagnoser på lokalitetsnivå (settefisk).
Perlesnormanet (Link: Artikkel i Norsk Veterinær Tidsskrift) har gitt høy dødelighet i de fleste regioner høsten 2023. Eksponering for perlesnormanet kan være en av årsakene til den økte forekomsten av karskader vi registrerer i høstmånedene. En god sykehistorie er derfor nødvendig for å kunne gi en mer nøyaktig årsakssammenheng og diagnose. Av alle innsendelser senhøsten 2023 der vi så gjelleforandringer som kunne relateres til eksponering for irriterende materiale i vannet, herunder maneter, var perlesnormanet oppgitt i sykehistorien i ca 45% av sakene. Hovedfunnene i disse sakene var milde til moderate lamellære karskader. I de sakene med mest alvorlige vevsskader så vi områder i gjellene med akutt til subakutt vevsdød (nekroser) av lameller og filament. Sammen med disse skadene så vi i enkelte gjeller tilsynelatende tomme runde strukturer med diameter på ca 13-15 μm og distinkt, refraktil kapsel. Vi tolker disse strukturene til å være nematocyster, det vil si giftkapsler perlesnormaneter bruker til å skade eller drepe fiender og byttedyr.
I mange av sakene med perlesnormanet oppgitt i sykehistorien ble det også påvist hudsår hvor de dominerende forandringene ofte var epiteltap og nekroser av hud (dermis). Skader på hud og gjeller forårsaket av maneter kan føre til sekundær bakteriell infeksjon, og i flere av våre saker påviste vi bakterier assosiert med vevsskadene, hvor filamentøse stavbakterier (Tenacibaculum-lignende) ofte var dominerende. Erfaringer fra senhøsten 2023 viser at vevsskadene perlesnormanet gir kan ha alvorlige konsekvenser for fiskens helse og velferd som videre kan føre til destruksjon eller utslakt av fisk med hensyn til fiskevelferd.

Bilde: Bildet viser vevssnitt fra gjeller fra laks i sjø etter angrep av perlesnormanet. Det ses runde strukturer med en diameter på ca 13-15 μm, tolket som nematocyster (målestrek), assosiert med nekroser (vevsdød) av gjellevevet.
PHARMAQ er verdens ledende selskap innen vaksiner og innovasjon rettet mot akvakulturnæringen og er en del av Zoetis, verdens ledende selskap innen dyrehelse. Våre innovative fiskehelseløsninger inkluderer et bredt spekter som fiskevaksiner, terapiprodukter, vaksinasjonsmaskiner inkludert servicetjenester, forskning og analyser. Selskapet leverer miljøvennlige, trygge og effektive helseprodukter til den globale akvakulturnæringen ved hjelp av målrettet forskning og engasjerte medarbeidere. Produksjon, administrasjon, forskning og utvikling ligger i Norge og med global virksomhet i kommersielle oppdrettsmarkeder har PHARMAQ rundt 375 medarbeidere. Konsernets produkter markedsføres i Europa, Nord- og Sør-Amerika samt i Asia. For mer informasjon, se selskapets hjemmeside: www.pharmaq.com. Personvernerklæring Erklæring om informasjonskapsler (cookies) Bruksvilkår
Copyright © 2020 Zoetis LLC. Alle rettigheter forbeholdt.